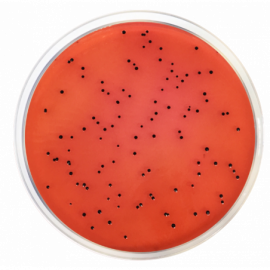

Môi trường nuôi cấy vi sinh XLD Agar (Xylose Lysine Desoxycholate Agar) ISO
Principles and uses
XLD Agar (Xylose Lysine Desoxycholate Agar) is prepared according to the formulation of the ISO 6579 norm. It is recommended for the identification of Salmonella in food products, after pre-enrichment in a non-selective fluid such as Buffered Peptone Water and enrichment in a selective fluid medium such as Muller Kauffmann Broth Base with Brilliant Green & Novobiocin (MKTTN), Rappaport Soy Broth (Vassiliadis) or Modified Semisolid Rappaport Vassiliadis Medium (MSRV).
The reactions are the degradation of the three fermentable carbohydrates: xylose, lactose, and sucrose, with the production of acid, manifested in the color change from red to yellow. Sodium thiosulfate serves as a reactive substance with Ferric ammonium citrate as an indicator of the formation of hydrogen sulfide under alkaline conditions. Lysine is included to enable the Salmonella group to be differentiated from the non-pathogens since, in its absence, salmonellae would quickly ferment the xylose, making it indistinguishable from non-pathogenic species. After the salmonellae terminate the xylose present, the lysine is attacked through the enzyme lysine decarboxylase with a change to an alkaline pH, similar to the Shigella reaction. The bacteria that decarboxylate the L-Lysine to cadaverine are identified by the presence of a purple-red color around the colonies due to the elevation of the pH. Phenol red is the pH indicator. Yeast extract is a source of vitamins, particularly of the B-group essential for bacterial growth. Sodium chloride supplies essential electrolytes for transport and osmotic balance. Sodium desoxycholate is the selective agent and is thus inhibitory to Gram-positive microorganisms. Bacteriological Agar is the solidifying agent.
Typical colonies of Salmonella on XLD agar have a black center and lightly transparent zone of reddish color due to the color change of the indicator.
Salmonella H2S-negative variants grown on XLD agar are pink with a darker pink center. Lactose-positive Salmonella grown on XLD agar are yellow with or without blackening.
Preparation
Suspend 54 grams of the medium in one liter of distilled water Mix well and dissolve by heating with frequent agitation. Boil for one minute until complete dissolution. AVOID OVERHEATING. DO NOT AUTOCLAVE.Cool the medium according to the applicable normative and pour into Petri dishes as soon as it has cooled.
Preparation of large volumes, overheating and prolonged storage in water bath is to be avoided. Precipitates may be formed but do not affect the performance of the culture media.